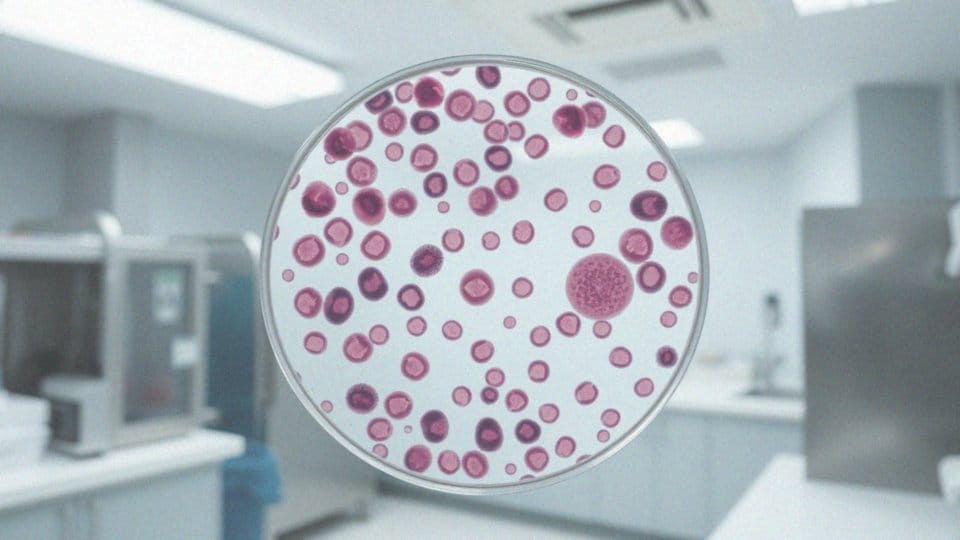

Spis treści
Co to jest grupa krwi?
Grupa krwi to ważna kategoria, która określa typ krwi danej osoby. Jej definicja opiera się na obecności specyficznych antygenów znajdujących się na powierzchni czerwonych krwinek. To dziedziczne cechy decydują o przynależności do określonego systemu, a wśród nich najbardziej znaczące to:
- układ AB0,
- układ Rh.
Wiedza na temat grupy krwi odgrywa kluczową rolę w krwiolecznictwie. Kiedy zachodzi potrzeba transfuzji, znajomość tego typu danych jest absolutnie niezbędna. Niezgodność grup krwi może wywołać poważne konsekwencje zdrowotne, dlatego tak ważne jest, aby każdy znał swoją grupę. Świadomość tych informacji ma znaczenie nie tylko w kontekście medycznym, ale także w życiu codziennym. Właściwe rozumienie własnej grupy krwi pomaga uniknąć problemów podczas zabiegów medycznych.
Jakie są różne grupy krwi?
Wyróżniamy cztery główne grupy krwi w układzie AB0: A, B, AB oraz 0. Każda z tych grup odznacza się obecnością lub brakiem określonych antygenów:
- grupa A zawiera antygen A,
- grupa B ma tylko antygen B,
- grupa AB ma oba te antygeny,
- grupa 0 nie posiada żadnego z nich.
Dodatkowo, system klasyfikacji krwi obejmuje również układ Rh, który dzieli grupy na RhD+ (z antygenem D) oraz RhD- (bez antygenu D). W rezultacie mamy osiem unikatowych grup krwi:
- A RhD+,
- A RhD-,
- B RhD+,
- B RhD-,
- AB RhD+,
- AB RhD-,
- 0 RhD+,
- 0 RhD-.
Zrozumienie tej różnorodności jest kluczowe, zwłaszcza w kontekście transfuzji krwi oraz potencjalnych konfliktów serologicznych. Ta wiedza może być nieoceniona w krytycznych sytuacjach, gdy konieczne jest przeprowadzenie transfuzji.
Jakie składniki zawiera krew?
Krew składa się z kilku kluczowych składników, które mają fundamentalne znaczenie dla prawidłowego funkcjonowania organizmu. Wśród nich wyróżniamy:
- Erytrocyty, powszechnie zwane krwinkami czerwonymi, odpowiadają za transport tlenu do komórek w ciele. Dzięki hemoglobinie, białku wiążącemu tlen w płucach, mogą efektywnie przekazywać go do tkanek,
- Leukocyty, czyli krwinki białe, są nieocenione dla systemu odpornościowego, eliminując infekcje oraz chroniąc przed różnymi chorobami. Wśród leukocytów wyróżniamy różne typy, takie jak limfocyty, monocyty czy granulocyty, które spełniają wyjątkową rolę w odpowiedzi immunologicznej,
- Trombocyty, znane również jako płytki krwi, odgrywają kluczową rolę w procesie krzepnięcia, zapobiegając nadmiernym stratom krwi w momencie urazu,
- Osocze, będące płynną częścią krwi, zawiera szereg składników, takich jak białka (np. albuminy i immunoglobuliny), elektrolity (sód, potas, wapń) oraz substancje odżywcze. Osocze jest niezbędne dla prawidłowego funkcjonowania całego organizmu,
- Antygeny obecne na powierzchni erytrocytów mają istotne znaczenie w klasyfikacji grup krwi, co jest szczególnie ważne w diagnostyce i transfuzjologii.
Jakie są popularne grupy krwi w Polsce?
W Polsce najpopularniejszą grupą krwi jest A RhD+, której nosiciele stanowią około 37% społeczeństwa. Na drugiej pozycji plasuje się 0 RhD+, występująca u około 33% ludzi. Rzadziej spotyka się grupy B RhD+ oraz AB RhD+, które obejmują odpowiednio 13% i 7% populacji. Najrzadsza jest grupa AB RhD-, występująca jedynie u 1% mieszkańców.
Taki rozkład grup krwi w naszym kraju odzwierciedla ich różnorodność, co ma istotne znaczenie, zwłaszcza w kontekście krwiodawstwa. Odpowiednia dostępność krwi do przetoczeń jest sprawą życia i śmierci. Osoby z grupą 0 RhD+ mają status uniwersalnych dawców, co oznacza, że mogą oddać krew każdemu potrzebującemu. Z drugiej strony, ci z grupą AB RhD- są uniwersalnymi biorcami, co pozwala im przyjmować krew z wszystkich grup.
Znajomość tych faktów jest niezwykle ważna, szczególnie w nagłych przypadkach, gdzie szybki dostęp do odpowiedniej grupy krwi może okazać się kluczowy dla ratowania życia.
Jak można określić grupę krwi?
Ustalenie grupy krwi odbywa się poprzez analizę próbki krwi. Niezbędne jest zidentyfikowanie antygenów A i B w systemie AB0 oraz antygenu D w systemie Rh, które są obecne na powierzchni erytrocytów. Wyznaczanie grupy krwi opiera się na zjawisku aglutynacji. W trakcie tego procesu do próbki dodawane są specjalne przeciwciała. Na przykład, gdy krew wykazuje reaktywność po dodaniu przeciwciał przeciwko antygenowi A, oznacza to, że ten antygen jest obecny, co wskazuje na przynależność pacjenta do grupy A.
Procedury te są szybkie, a wyniki można uzyskać w zaledwie kilka minut. Standardowe testy przeprowadzane są w:
- szpitalach,
- klinikaach,
- punktach pobrań krwi.
To pozwala pacjentom na błyskawiczne poznanie swojej grupy krwi. Znajomość tego ważnego szczegółu bywa niezwykle pomocna, nie tylko podczas transfuzji, lecz także w codziennym życiu, zwłaszcza w sytuacjach nagłych związanych ze zdrowiem.
Na czym polega badanie grupy krwi?
Badanie grupy krwi polega na rozpoznawaniu antygenów obecnych na czerwonych krwinkach, co jest kluczowe dla zdefiniowania przynależności do konkretnego układu. W tym procesie analizuje się antygeny A, B oraz D, które są podstawą klasyfikacji w systemach ABO oraz Rh. W praktycznych warunkach, do próbki krwi pacjenta dodaje się przeciwciała anty-A, anty-B oraz anty-D. Gdy dochodzi do aglutynacji, czyli zlepiania się krwinek, możemy wnioskować o obecności danego antygenu. Przykładowo, jeżeli po dodaniu przeciwciał anty-A zaobserwujemy aglutynację, oznacza to, że pacjent ma grupę A.
Tego typu badania są realizowane w:
- szpitalach,
- klinikach,
- punktach pobrań krwi.
To czyni je szybkim i bezpiecznym procesem. Zrozumienie, jak przebiega badanie grupy krwi, ma znaczenie nie tylko w kontekście medycznym, ale również w codziennym życiu. Świadomość własnej grupy krwi może znacząco wpływać na podejmowane decyzje zdrowotne oraz stanowić istotny element bezpieczeństwa w sytuacjach awaryjnych.
Jakie są metody wykonania badania grupy krwi?
Badanie grupy krwi zazwyczaj realizuje się za pomocą metod serologicznych, w szczególności techniki aglutynacyjnej. Proces ten polega na mieszaniu próbki krwi z surowicami zawierającymi znane przeciwciała, takie jak:
- anty-A,
- anty-B,
- anty-D.
Na przykład, jeśli krew pacjenta reaguje z przeciwciałami anty-A, dochodzi do aglutynacji, co potwierdza obecność antygenu A. W rezultacie możemy stwierdzić, że pacjent należy do grupy A. Badanie można przeprowadzić zarówno na płytce, jak i w probówce; ta pierwsza opcja jest często szybsza, ponieważ pozwala na jednoczesną analizę większej liczby próbek. Testy te są wykonywane w szpitalach, klinach oraz w punktach krwiodawstwa, a czas oczekiwania na wyniki zwykle jest krótki i komfortowy dla pacjentów. Cała procedura cechuje się wysokim poziomem bezpieczeństwa i efektywności.
Zauważalny jest także wzrost popularności metod erystycznych, takich jak zastosowanie przeciwciał monoklonalnych, co przyczynia się do zwiększenia precyzji uzyskiwanych wyników. Badanie grupy krwi odgrywa istotną rolę nie tylko w kontekście transfuzji, ale również w diagnostyce oraz planowaniu odpowiednich procedur medycznych dla pacjentów.
Kiedy powinno się wykonać badanie grupy krwi?
Zrozumienie swojej grupy krwi ma kluczowe znaczenie w wielu okolicznościach. Przede wszystkim, przed zabiegami chirurgicznymi i transfuzjami krwi, to badanie jest absolutnie konieczne, aby uniknąć niebezpiecznych niezgodności, które mogą zagrażać życiu pacjenta.
W przypadku ciąży badanie to nabiera szczególnego znaczenia, ponieważ pozwala na wykrycie ewentualnego konfliktu serologicznego między matką a jej dzieckiem. W nagłych wypadkach, takich jak akcje ratunkowe czy pilne operacje, błyskawiczne ustalenie grupy krwi odgrywa niezwykle ważną rolę – opóźnienia w tym zakresie mogą prowadzić do poważnych komplikacji zdrowotnych.
Dlatego znajomość własnej grupy krwi jest kluczowa dla skutecznego zarządzania zdrowiem i zapewnienia sobie bezpieczeństwa, zarówno w codziennych sytuacjach medycznych, jak i podczas kryzysów. Osoby rozważające oddanie krwi powinny zadbać o wykonanie tego badania, co znacznie podnosi bezpieczeństwo transfuzji oraz ułatwia zarządzanie danymi w systemie krwiodawstwa.
Jak długo czeka się na wynik badania grupy krwi?

Czas oczekiwania na wyniki testu grupy krwi różni się w zależności od sposobu przeprowadzenia badania. Przy badaniach planowych pacjenci zazwyczaj otrzymują rezultaty w ciągu kilku dni roboczych. W nagłych sytuacjach, gdzie kluczowe jest szybkie przetoczenie krwi, wyniki mogą być uzyskane w trybie pilnym, co pozwala na ich zdobycie w zaledwie kilkanaście minut. Taki krótki czas jest niesamowicie istotny, ponieważ każda sekunda ma ogromne znaczenie w ratowaniu życia pacjentów, którzy potrzebują natychmiastowej interwencji medycznej.
Dodatkowo osoby oddające krew powinny być świadome, jak długo trzeba czekać na wyniki, ponieważ ma to wpływ na proces krwiodawstwa oraz późniejsze zastosowanie krwi w lecznictwie.
Jakie znaczenie ma układ AB0 i układ Rh w diagnostyce grupy krwi?
Układ AB0 oraz układ Rh mają kluczowe znaczenie w diagnostyce grup krwi i pomagają ocenić ryzyko wystąpienia konfliktów serologicznych. Układ AB0 odpowiada za identyfikację antygenów A i B na powierzchni erytrocytów, natomiast układ Rh wskazuje obecność antygenu D. Te informacje są niezwykle ważne w przypadku transfuzji, ponieważ niezgodność grup krwi może prowadzić do groźnych reakcji immunologicznych, zagrażających życiu pacjenta.
Zrozumienie tych układów jest również istotne w kontekście ciąży. Konflikt serologiczny, który może wystąpić, gdy matka należy do grupy Rh- a dziecko do Rh+, może prowadzić do poważnych schorzeń, takich jak choroba hemolityczna noworodka. Dlatego wczesne rozpoznanie oraz odpowiednia interwencja medyczna są niezbędne, by zapewnić bezpieczeństwo dziecka.
Ustalenie grupy krwi, zarówno w układzie AB0, jak i Rh, powinno być przeprowadzane różnymi metodami, na przykład poprzez testy aglutynacji z zastosowaniem odpowiednich przeciwciał. Te procedury są szybkie, a ich wyniki niezwykle istotne w nagłych sytuacjach oraz podczas transfuzji planowych.
Osoby z grupą 0 RhD+ są uznawane za uniwersalnych dawców, co oznacza, że ich krew można podać każdemu pacjentowi. Z kolei osoby z grupą AB RhD- mogą przyjmować krew od wszystkich grup, co czyni ich uniwersalnymi biorcami. Takie informacje mają istotny wpływ na organizację krwiodawstwa i skuteczność działań medycznych związanych z transfuzjami.
Jakie przeciwciała występują w różnych grupach krwi?

Osoby z różnymi grupami krwi dysponują charakterystycznymi przeciwciałami, które odgrywają kluczową rolę w diagnostyce oraz transfuzjologii. Na przykład, ci, którzy mają grupę krwi A, w swoim osoczu posiadają przeciwciała anty-B. To sprawia, że ich organizm jest wrażliwy na krew zawierającą antygen B. Z kolei osoby z grupą krwi B produkują przeciwciała anty-A, co oznacza, że nie mogą przyjmować krwi z antygenem A.
Grupa 0 jest szczególna, ponieważ jej nosiciele mają zarówno przeciwciała anty-A, jak i anty-B. Właśnie dlatego są uznawani za uniwersalnych dawców, jednak mogą otrzymywać krew jedynie od innych osób z tą samą grupą. Natomiast osoby z grupą krwi AB są pozbawione zarówno przeciwciał anty-A, jak i anty-B, co czyni ich uniwersalnymi biorcami — mogą przyjmować krew od każdej z grup.
Warto również wspomnieć o osobach z grupą RhD-, które mogą wytworzyć przeciwciała anty-D w przypadku kontaktu z krwią RhD+. Taki stan rzeczy może prowadzić do poważnych komplikacji podczas transfuzji. Dlatego tak ważne jest, aby posiadać wiedzę na temat układu Rh oraz przeciwciał, co pozwala na zapewnienie bezpieczeństwa pacjentom, zwłaszcza w sytuacjach, gdy niezgodność grup krwi stanowi zagrożenie dla życia.
Jakie są konsekwencje niezgodności grupy krwi przy transfuzji?
Przetaczanie krwi, która nie odpowiada grupie biorcy, może skutkować poważnymi zagrożeniami zdrowotnymi. Kiedy erytrocyty z innej grupy są wprowadzone do organizmu, system odpornościowy może zareagować, traktując te komórki jako obce. Taki immunologiczny atak prowadzi do hemolizy, czyli rozpadu czerwonych krwinek, co z kolei rodzi groźne konsekwencje. Może pojawić się wstrząs transfuzjowy, który objawia się:
- obniżeniem ciśnienia krwi,
- zaburzeniami w krążeniu.
Dodatkowo, uwolnienie hemoglobiny do krwi może wpływać na funkcjonowanie nerek, prowadząc do ich niewydolności. W skrajnych przypadkach, jeżeli nie zostaną podjęte odpowiednie kroki, może niestety dojść do śmierci pacjenta. Z tego względu kluczowe jest, aby dokładnie zweryfikować kompatybilność grupy krwi oraz starannie przygotować się do transfuzji. Przed każdym przetoczeniem niezbędne są testy, które potwierdzą zgodność krwi z grupą biorcy, co w znacznym stopniu ogranicza możliwość wystąpienia niebezpiecznych reakcji immunologicznych. W przypadku jakichkolwiek wątpliwości lub informacji o alergiach warto przeprowadzić dodatkowe badania przed dokonaniem transfuzji.
Co to jest konflikt serologiczny i jak można mu zapobiec?
Konflikt serologiczny to zjawisko zachodzące, gdy matka z grupą krwi RhD- spodziewa się dziecka z grupą RhD+. W momencie, gdy krew malucha, która zawiera antygen D, dostaje się do organizmu matki, może to wywołać jej reakcję w postaci produkcji przeciwciał anty-D. Te przeciwciała mogą następnie zaatakować czerwone krwinki dziecka RhD+, co prowadzi do poważnych zagrożeń zdrowotnych, takich jak:
- choroba hemolityczna noworodka,
- inne komplikacje zdrowotne.
Aby zapobiec konfliktowi serologicznemu, kobietom z grupą RhD- podawana jest immunoglobulina anty-D. Podaje się ją po porodzie, jeśli noworodek ma grupę RhD+, lub po innych interwencjach medycznych, które mogą skutkować wymianą krwi między matką a dzieckiem. Profilaktyka odgrywa kluczową rolę, gdyż odpowiednie działania mogą uratować życie noworodka oraz wspierać zdrowie matki. Wczesne wykrycie potencjalnego konfliktu oraz natychmiastowa interwencja medyczna są niezbędne dla bezpieczeństwa zarówno matki, jak i dziecka. Edukacja na temat konfliktu serologicznego oraz podnoszenie świadomości o możliwych zagrożeniach powinny być ważną częścią opieki prenatalnej. Dlatego warto porozmawiać z lekarzem, aby w pełni zrozumieć tę sytuację i jej konsekwencje.
Jakie są przyczyny choroby hemolitycznej noworodka?

Choroba hemolityczna noworodka zazwyczaj pojawia się w wyniku konfliktu serologicznego między matką a jej dzieckiem, szczególnie w kontekście czynnika Rh. Kiedy matka ma grupę krwi RhD- i rodzi malucha z grupą RhD+, czerwone krwinki płodu mogą przenikać do jej krwi. W rezultacie organizm matki zaczyna produkować przeciwciała anty-D, które z kolei atakują krwinki czerwone dziecka, prowadząc do ich hemolizy. Taki proces może skutkować poważnymi problemami, takimi jak:
- niedokrwistość,
- żółtaczka,
- ryzyko uszkodzenia neurologicznego.
W przypadku ciężkiej postaci choroby hemolitycznej konieczna bywa natychmiastowa interwencja medyczna oraz dostosowanie metod leczenia w neonatologii. Kluczowe jest szybkie zidentyfikowanie zagrożenia i wdrożenie odpowiednich działań, co pozwala znacznie zmniejszyć ryzyko długotrwałych komplikacji zdrowotnych u noworodków dotkniętych konfliktem serologicznym. Zrozumienie tej patologii oraz jej przyczyn ma zasadnicze znaczenie dla zdrowia zarówno matki, jak i dziecka.
Kiedy możliwe jest, że grupa krwi ulegnie zmianie?
Grupa krwi zazwyczaj nie ulega zmianom w ciągu życia danej osoby. Istotne modyfikacje mogą zdarzyć się jedynie w nielicznych przypadkach, takich jak:
- przeszczep szpiku kostnego,
- który powoduje, że biorca przyjmuje grupę krwi dawcy,
- białaczki,
- inne schorzenia dotyczące układu krwiotwórczego.
Kluczowe jest dobranie odpowiedniego dawcy, co znacząco zmniejsza ryzyko reakcji immunologicznych. Warto również pamiętać, że poza tymi wyjątkowymi sytuacjami, grupa krwi pozostaje niezmienna przez całe życie. Precyzyjna identyfikacja grupy krwi ma duże znaczenie, zwłaszcza w kontekście transfuzji oraz innych procedur medycznych, dlatego też ustalenie jej przed jakimikolwiek interwencjami terapeutycznymi jest tak istotne.
Jakie znaczenie dla zdrowia ma znajomość grupy krwi?
Znajomość swojej grupy krwi ma ogromne znaczenie w różnych sytuacjach związanych ze zdrowiem. Przede wszystkim, jest to kluczowy element podczas transfuzji krwi, gdzie zgodność grup krwi może decydować o życiu pacjenta. Kiedy grupy nie pasują, mogą wystąpić poważne reakcje organizmu, jak hemoliza czy wstrząs transfuzjowy, które stwarzają realne zagrożenie dla życia.
Co więcej, informacja o grupie krwi staje się ważna w kontekście planowania rodziny. W przypadku, gdy matka posiada grupę RhD-, a dziecko RhD+, może dojść do konfliktu serologicznego, co prowadzi do ryzyka choroby hemolitycznej u noworodka. Wczesne określenie grupy krwi oraz adekwatne metody leczenia mogą skutecznie zapobiec tym poważnym problemom.
Badania sugerują, że znajomość grupy krwi może wpływać także na ryzyko niektórych schorzeń, takich jak choroby sercowo-naczyniowe. Choć związek ten nie został definitywnie potwierdzony, świadomość na ten temat może skłonić nas do podejmowania zdrowszych wyborów.
W sytuacjach kryzysowych, takich jak interwencje ratunkowe, szybkie przekazanie informacji o grupie krwi jest niezbędne dla skutecznej pomocy medycznej. Dlatego tak ważne jest, aby każdy wiedział, jaką grupę krwi posiada, co może ułatwić dostęp do opieki w nagłych przypadkach.
Co to jest karta identyfikacyjna grupy krwi?
Karta Identyfikacyjna Grupy Krwi to ważny dokument, który poświadcza grupę krwi danej osoby. Zawiera kluczowe dane, w tym wyniki w systemach AB0 oraz Rh (D). Jest to szczególnie istotne w nagłych sytuacjach medycznych. Na przykład, w trakcie transfuzji krwi wiedza o grupie krwi może okazać się decydująca dla ratowania życia.
Posiadanie Karty umożliwia szybkie potwierdzenie grupy krwi, co znacząco przyspiesza pomoc medyczną w krytycznych momentach. Wypełnianie Karty opiera się na wynikach uzyskanych z rzetelnych laboratoriów. Zapisy są dokonywane po dwóch niezależnych badaniach, co zapewnia wysoką dokładność danych.
Karta nie tylko pełni funkcję informacyjną, ale także formalną, stanowiąc oficjalne potwierdzenie grupy krwi, co jest kluczowe w przypadku transfuzji. Dzięki jej zastosowaniu korzyści odnoszą nie tylko pacjenci, ale również personel medyczny, ponieważ Karta minimalizuje ryzyko błędów przy transfuzjach.
Zwiększenie świadomości na temat tego dokumentu może znacznie poprawić organizację działań związanych z krwiolecznictwem oraz zapewnić większe bezpieczeństwo pacjentom.


